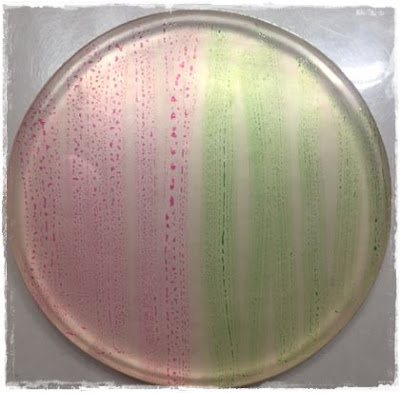

Hallo allemaal,
Al in een eerder bericht heb ik jullie laten zien dat je stempels kunt inkleuren met de Molotow Aqua Twin Markers. Vandaag pas ik deze techniek nogmaals toe, maar laat ik ook zien dat je de Aqua Twin Markers ook kunt gebruiken om een achtergrondje te maken op de Gelli Plate.
Wat heb je nodig:
- ronde Gelli Plate 4 inch
-aquarelpapier
-squeeze pen
- twee kleuren Molotow Aqua Twin markers
- brayer
- mask
- aquarelpotloden ( ik heb de Derwent Inktense gebruikt)
Zet met de beitelpunt van je marker een aantal strepen op je Gelli Plate.
Rol dan met de brayer in de richting van de strepen.
Als je een mooie egale kleur hebt op de Plate, plaats je je mask van je keuze erop.
Rol nog een aantal keer met de brayer erover, met bijna geen druk.
Haal het mask voorzichtig in 1 beweging eraf .
Dan is dit het resultaat.
Voor je nu aan de afwerking gaat beginnen, eerst stempelen. Dan zie je veel beter wat er straks geaccentueerd kan worden.
Leg je achtergrondje in je stempelhulp. Dat is wel het beste met deze techniek.
Dan kan je meerdere keren afdrukken en weet je zeker dat de stempel weer op de juiste plek wordt gestempeld.
Kleur de delen van de stempel naar je eigen idee.
Ik heb gekozen om per kleur te stempelen.
Nadat je tevreden bent over je stempelafdruk, kan je beginnen met de achtergrond te bewerken.
Sommige delen van de mask afdruk ga ik accentueren door ze licht met de Derwent Aquarel Inktense potloden aan te zetten. Dan neem je een licht vochtige Squeeze pen en laat de kleur mooi uitvloeien.
Nadat dit droog is, kan je met een witte Molotow Marker stipjes zetten om wat meer diepte te geven.
Met plakpareltjes, Liquidpearls en Frantage Silver Halo Mix glitter het geheel afgemaakt.
Het leuke van deze techniek is dat de kleur van je achtergrond en je stempel hetzelfde zijn en ze geweldig mooi matchen.
Veel plezier met jullie eigen creaties.

Geen opmerkingen:
Een reactie posten